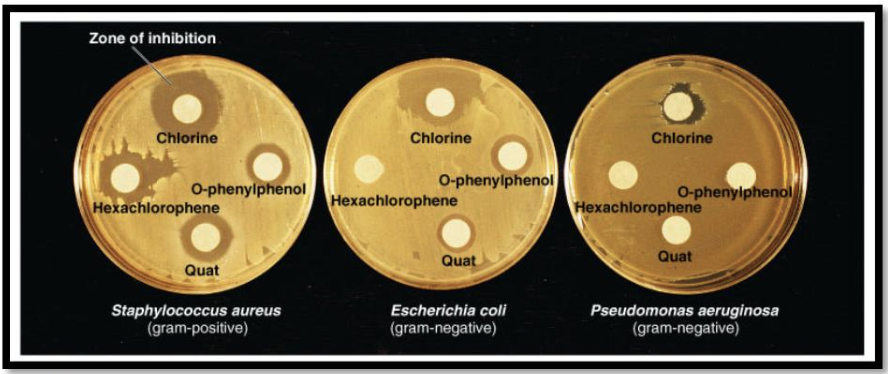
<p><span style="font-size: medium;">The procedure to study the effectiveness of antimicrobial substances utilizes this method</span></p><p>a. free radicals to inhibit microbial growth</p><p>b. disk diffusion method</p><p>c. moist heat sterilization</p><p>d. excision repair</p>

Pretest 2 Microbiology: PowerPoints 4 Growth and Control and PowerPoint 5 Metabolism
1/48
There's no tags or description
Looks like no tags are added yet.
Name | Mastery | Learn | Test | Matching | Spaced | Call with Kai |
|---|
No analytics yet
Send a link to your students to track their progress
49 Terms
The plasmid used to genetically modify plants comes from this plant pathogen
a. Rhizobium radiobacter
b. Escherichia coli
c. Bacillus megaterium
d. Staphylococcus aureus
a. Rhizobium radiobacter

Obligate aerobe microbes live best
a. in an anaerobic environment
b. where atmospheric oxygen is present
c. when no oxygen is present
d. with or without the presence of oxygen
b. where atmospheric oxygen is present
The elements chlorine and iodine are
a. compose ozone molecule
b. antibiotics
c. antimicrobial
d. artificial sweeteners
c. antimicrobial
Sulfanilamide drugs are antimicrobial because they interfere with
a. metabolic pathways
b. nucleic acid synthesis
c. cell wall synthesis
d. protein synthesis
a. metabolic pathways

Insulin today is predominantly made this way
a. recombinant DNA technology
b. decomposition of organic matter
c. Bacillus thuringensis
d. the nitrogen cycle
a. recombinant DNA technology
The procedure to study the effectiveness of antimicrobial substances utilizes this method
a. free radicals to inhibit microbial growth
b. disk diffusion method
c. moist heat sterilization
d. excision repair
b. disk diffusion method
Which statement is true concerning penicillin?
a. effective against protozoa
b. effective against fungi
c. destroys peptidoglycan of the cell wall in bacteria
d. is less effective against Gram-positive than Gram-negative bacteria
c. destroys peptidoglycan of the cell wall in bacteria
Fungi are not affected by penicillin because they lack
a. chloroplasts
b. peptidoglycan in their cell walls
c. sterols in their cell membranes
d. ribosomes
b. peptidoglycan in their cell walls
Competitive inhibitors stop enzyme action by binding to
a. the product
b. any site along the enzyme
c. the substrate
d. the active site of the enzyme
d. the active site of the enzyme
The method to study antimicrobial substances is named after
a. Davson-Danielli
b. Kirby-Bauer
c. Watson-Crick
d. Singer-Nicholson
b. Kirby-Bauer

The cleanup of toxic oil in the environment is called
a. bioterrorism
b. nitrogen fixation
c. bioremediation
d. excision repair
c. bioremediation

Bacillus thuringiensis
a. is used commercially to synthesize ethanol
b. causes crown gall in plants
c. produces a natural insecticide toxic to insects
d. is a nitrogen fixing bacterium
c. produces a natural insecticide toxic to insects

Aerotolerant microorganisms
a. are anaerobic but able to live in the presence of oxygen
b. need atmospheric levels of oxygen to survive
c. require a reduced amount of oxygen to survive
d. are aerobic
a. are anaerobic but able to live in the presence of oxygen
A microorganism that does not have the enzymes catalase or superoxide dismutase would find
it difficult to live in an environment containing
a. carbon dioxide
b. oxygen
c. high salt
d. temperatures above 37° C
b. oxygen
An antibiotic that injures the bacteria plasma membranes is
a. rifampin
b. erythromycin
c. bacitracin
d. polymyxin B
d. polymyxin B

This bacteria is most likely to spoil refrigerated foods
a. halophiles
b. thermophiles
c. psychrotrophs
d. mesophiles
c. psychrotrophs
Which antibiotic binds to the 50s portion of the ribosome and inhibits the
formation of the peptide bond?
a. streptomycin
b. rifampin
c. chloramphenicol
d. penicillin
e. erythromycin
c. chloramphenicol
Cultures of bacteria were incubated on the shelf of a refrigerator, on a lab bench
at 20° C, in a 37° C incubator, and a 50° C incubator. After incubation, there was no growth
at 37° C and 50° C, slight growth out on the benchtop, and abundant growth at refrigeration.
What term could be used for these bacteria?
a. halophile
b. psychrotroph
c. mesophile
d. anaerobe
b. psychrotroph
Microorganisms living around deep sea hydrothermal vents are
a. psychrophiles
b. extreme halophiles
c. mesophiles
d. hyperthermophiles
d. hyperthermophiles
Most human diseases are caused by microorganisms in this grouping
a. psychrophiles
b. hyperthermophiles
c. psychrotrophs
d. mesophiles
d. mesophiles
Microorganisms that survive in 35% salt water are
a. hyperthermophiles
b. extreme halophile
c. obligate aerobes
d. acidophiles
b. extreme halophile
Microorganism found thriving in a the permafrost region of the Arctic are
a. halophiles
b. mesophiles
c. acidophiles
d. aerotolerant
e. psychrophiles
e. psychrophiles
Facultative halophiles
a. are photosynthetic
b. tolerate high acidic environments
c. tolerate elevated salt concentrations from 7.5% to 10%
d. can only grow in an oxygen rich environment
e. can thrive at temperatures as low as 0 degrees Celsius
c. tolerate elevated salt concentrations from 7.5% to 10%
Most bacteria prefer to grow at which pH range?
a. 1.0 to 3.0
b. 3.5 to 5.5
c. 6.5 to 7.5
d. 7.5 to 10.0
c. 6.5 to 7.5
. If 1 mL of bacteria from an original culture is transferred from a stock
culture to 99 mL of sterile broth, then 1mL of the broth culture is transferred
to 99 mL of a second broth culture, how much has the original culture been
diluted?
a. 1:10
b. 1:100
c. 1:1,000
d. 1:10,000
d. 1:10,000
Microorganisms that survive at pH of 4.0 are considered
a. facultative halophiles
b. acidophiles
c. psychrotrophs
d. mesophiles
e. facultative anaerobes
b. acidophiles

Pyrimidine dimers form in DNA when
a. exposed to very low temperatures
b. UV radiation is absorbed by the base thymine
c. subjected to ethylene oxide
d. they comes in contact bisphenols
b. UV radiation is absorbed by the base thymine
Alkaliphiles are best found at this pH
a. pH 2
b. pH 4
c. pH 7
d. pH 11
d. pH 11

Why are catalase and peroxidases enzymes important to living cells?
a. they retard the growth a microorganisms in prepared foods
b. they are antibiotics
c. they return nitrogen back into soil in the useable form of nitrates and nitrites
d. they destroy free radicals
d. they destroy free radicals
The Great Oxidation Event was a game changer for all of these responses except
a. it was at a time when the Earth's atmosphere and the shallow oceans began to experience a
significant rise of oxygen
b. the mass extinction that followed was far reaching, causing almost all life on Earth to go
extinct
c. all anaerobic microorganisms went extinct
d. it was a time when microorganisms had to adapt to oxygen, become aerobic, or die
c. all anaerobic microorganisms went extinct
Heavy metals such as zinc, silver, mercury, copper and aluminum kill microorganisms by
a. acting as surfactants
b. oligodynamic action
c. acting as a chemical food preserver
d. de-germ skin
b. oligodynamic action

Microorganisms that use oxygen but in lesser amounts than obligate aerobes are
a. aerotolerant anaerobes
b. microaerophiles
c. strict anaerobes
b. microaerophiles
Pyrimidine dimers generally form between these two bases
a. A and A
b. C and G
c. T and T
d. G and A
c. T and T
All are enzymes characteristics except
a. are affected by the pH of the environment
b. work at an optimum temperature
c. specific in their reactions
d. reacts with the product to form the substrate
d. reacts with the product to form the substrate
All are true about NADH except
a. is a B vitamin derivative
b. is reduced in this form
c. is indirectly responsible for producing 3 ATP
d. is oxidized in this form
d. is oxidized in this form

The final electron acceptor molecule during electron transport is
a. FAD
b. oxygen
c. ATP
d. pyruvic acid
b. oxygen
What is the net gain of ATP during glycolysis?
a. 2 ATP
b. 4 ATP
c. 6 ATP
d. no oxygen is produced during glycolysis
a. 2 ATP
The energy used to pump protons (H+) across the cristae membrane and into the intramembrane space comes from
a. ATP
b. electron potential energy as they are transported through the cristae membrane
c. ADP
d. water
b. electron potential energy as they are transported through the cristae membrane
In aerobic bacteria, how many ATP are produced from one glucose molecule
a. 2 ATP
b. 12 ATP
c. 24 ATP
d. 38 ATP
d. 38 ATP
All of the following pertain to ethyl alcohol respiration except
a. produces carbon dioxide
b. occurs in yeast
c. produces 2 ATP
d. requires oxygen
d. requires oxygen
To make NADH, NAD must gain
a. two protons
b. one proton and two electrons
c. three protons and one electron
d. two electrons
b. one proton and two electrons
Noncompetitive inhibitors stop enzyme action by binding to
a. the product
b. the enzyme other than the active site
c. the substrate
d. the active site of the enzyme
b. the enzyme other than the active site
All of the following pertain to the Krebs cycle except a. occurs without oxygen
b. begins with the acetyl molecule
c. ends with formation of pyruvic acid
d. produces 2 ATP by substrate level phosphorylation
c. ends with formation of pyruvic acid
Catalase functions to
a. convert hydrogen peroxide to oxygen and water
b. stop PABA from completing its biochemical pathway
c. make ATP
d. convert glucose to pyruvic acid
a. convert hydrogen peroxide to oxygen and water
A catabolic reaction is
a. protein digestion
b. photosynthesis
c. protein synthesis
d. starch synthesis
a. protein digestion
Oxygen is required during aerobic respiration to
a. makes ATP
b. pump protons across the membrane during electron transport
c. removes electrons as they leave the electron transport chain
d. form pyruvic acid
c. removes electrons as they leave the electron transport chain
The ATP making machine in the cristae membrane is
a. acetyl co-enzyme A
b. ATP synthase
c. FADH2
d. oxygen
b. ATP synthase
One NADH indirectly makes how many ATPs during electron transport?
a. two ATP
b. three ATP
c. four ATP
d. none
b. three ATP
All are connected to ethyl alcohol fermentation except
a. anaerobic respiration
b. fermentation
c. carbon dioxide produced
d. requires oxygen
d. requires oxygen